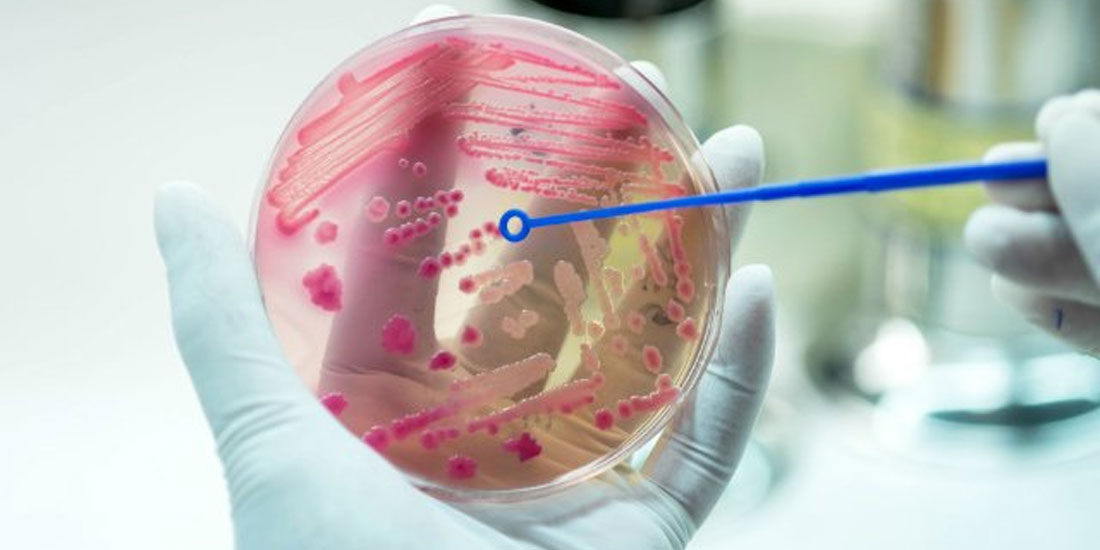
Ένας στους πέντε θανάτους κάθε χρόνο παγκοσμίως σχετίζονται με τη σήψη

Διπλάσιοι άνθρωποι, σε σχέση με όσους εκτιμάτο έως τώρα, πεθαίνουν από σήψη στον κόσμο, σύμφωνα με μια νέα διεθνή επιστημονική έρευνα, την πιο ολοκληρωμένη του είδους της μέχρι σήμερα. Εκτιμάται πλέον ότι κάθε χρόνο περίπου ένας στους πέντε θανάτους παγκοσμίως σχετίζεται με τη σήψη και πολλοί από αυτούς αφορούν παιδιά σε φτωχές χώρες.
Οι ερευνητές των Ιατρικών Σχολών του Πίτσμπουργκ και της Ουάσιγκτον, με επικεφαλής την επίκουρη καθηγήτρια Κριστίνα Ρουντ, που ανέλυσαν στοιχεία για 195 χώρες και έκαναν τη σχετική δημοσίευση στο ιατρικό περιοδικό “The Lancet”, υπολόγισαν 48,9 εκατομμύρια ετήσιες περιπτώσεις σήψης παγκοσμίως και 11 εκατομμύρια θανάτους εξαιτίας της σήψης, περίπου το 20% των συνολικών θανάτων. Οι θάνατοι από σήψη είναι περισσότεροι από τους θανάτους λόγω καρκίνου (9,6 εκατομμύρια το 2018 σύμφωνα με τον Παγκόσμιο Οργανισμό Υγείας).
Οι προηγούμενες εκτιμήσεις για 19 εκατομμύρια περιστατικά σήψης και πέντε εκατομμύρια θανάτους ετησίως βασίζονταν κυρίως σε στοιχεία από τις ανεπτυγμένες χώρες και υποεκτιμούσαν το μέγεθος του προβλήματος στις υπόλοιπες.
Η σήψη -γνωστή και ως «κρυφός δολοφόνος»- συμβαίνει όταν τα όργανα του ανθρώπου σταματούν να λειτουργούν κανονικά εξαιτίας μιας ανεξέλεγκτης αντίδρασης του ανοσοποιητικού συστήματος σε κάποια λοίμωξη από βακτήριο ή ιό. Η κύρια αιτία θανάτου από σήψη είναι η πνευμονία. Ακόμη και αν η σήψη δεν οδηγήσει τελικά σε θάνατο, μπορεί να δημιουργήσει μόνιμες αναπηρίες και άλλα χρόνια προβλήματα στους επιζήσαντες.
Η πλειονότητα των περιστατικών σήψης (περίπου το 85%) συμβαίνουν σε χώρες χαμηλού και μεσαίου εισοδήματος. Τα μεγαλύτερα ποσοστά υπάρχουν στην υποσαχάρια Αφρική, στα νησιά του Νοτίου Ειρηνικού και στην νοτιοανατολική Ασία. Η σήψη είναι συχνότερη στις γυναίκες από ό,τι στους άνδρες και τα περισσότερα περιστατικά (πάνω από το 40%) συμβαίνουν σε μικρά παιδιά έως πέντε ετών.
Πάντως, σύμφωνα με τη μελέτη, η κατάσταση βελτιώνεται διαχρονικά, καθώς το 1990 οι περιπτώσεις σήψης εκτιμώντο σε 60,2 εκατομμύρια ετησίως και οι θάνατοι εξαιτίας της σε 15,7 εκατομμύρια. Η βελτίωση των συνθηκών υγιεινής, το καθαρό πόσιμο νερό, οι εμβολιασμοί και η έγκαιρη χορήγηση φαρμάκων παίζουν σημαντικό ρόλο στην αποφυγή της σήψης.